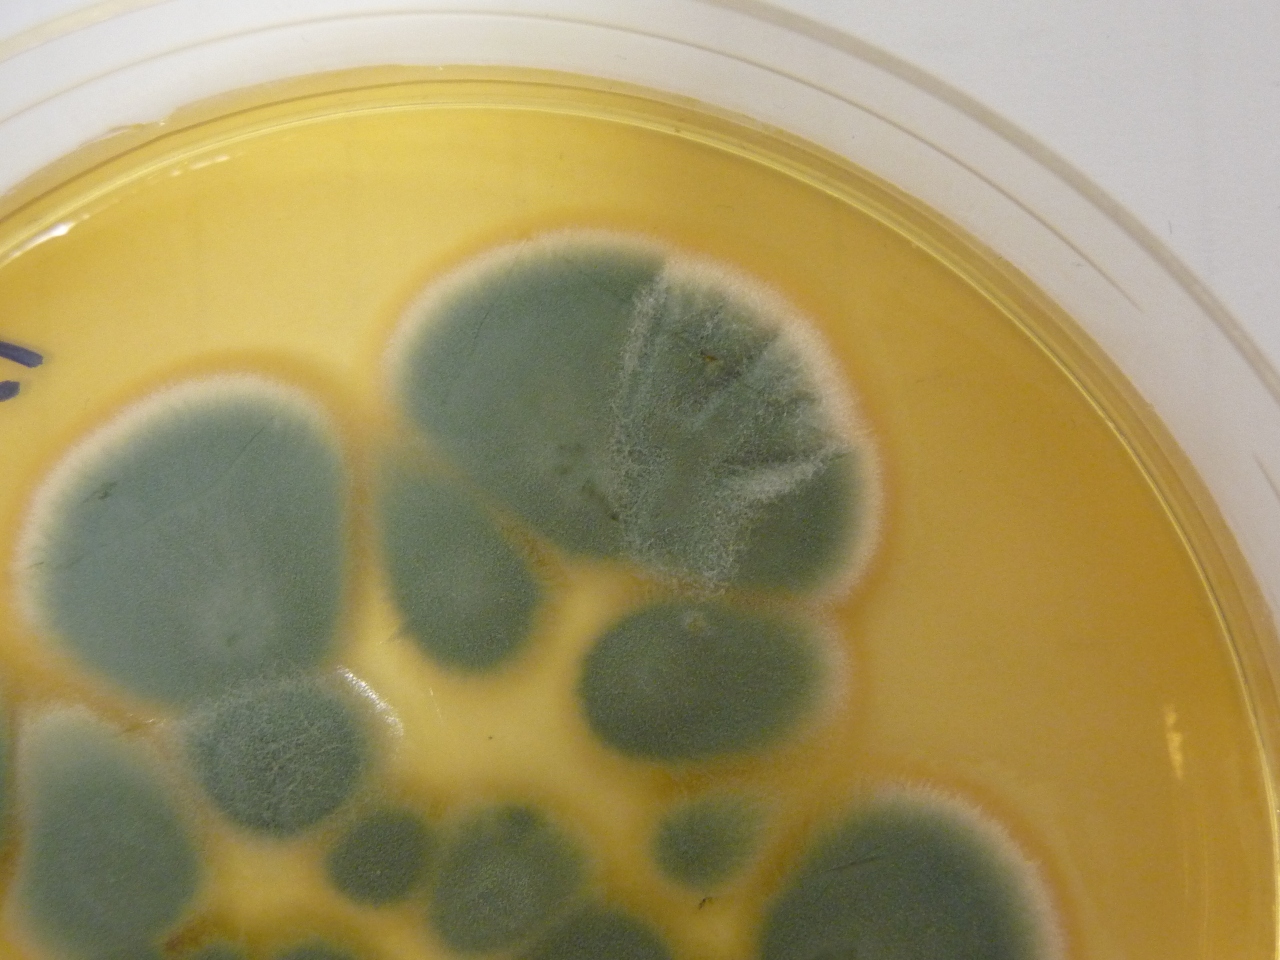

“E haja pó sobre toda a terra do Egito, donde resultarão nos homens e nos animais tumores por toda a terra do Egito” (Êxodo; 9:9).
A frase bíblica acima, que profetiza o terror causado pelo Bacillus anthracis como uma das dez pragas enviadas por Deus sobre o Egito, nos mostra que as infecções sempre tiveram uma relação estreita com a história da humanidade.
Os Papiros egípcios de Ebers e de Edwin Smith, escritos até três mil anos antes de Cristo, citavam tratamento dado às feridas infectadas, que pela falta de conhecimentos da época, eram associadas à presença de maus espíritos ou por castigo dos deuses. O livro de Samuel, pertencente ao Antigo Testamento, relatou o surto de peste bubônica que dizimou a população da cidade de Asdod. A falta de conhecimento associado ao misticismo fazia com que tais infecções fossem tratadas com carne fresca, misturas à base de mel, ervas e outras poções “milagrosas”. Com a tradicional sabedoria chinesa surgiu o que se acredita ter sido o primeiro antibiótico natural: uma “coalhada” de soja embolorada (olha o fungo ai!). Outro modo de se tratar ferimentos infeccionados na época era a utilização de teias de aranhas e pão embolorado. As pestes e surtos trouxeram ao ser humano séculos e séculos de horror causado por doenças infecciosas.

A confecção do Papiro de Ebers, do qual se desconhece o autor. O Sacerdote comanda a preparação dos remédios, função equivalente à do boticário (atual farmacêutico). Ao lado, o escriba anota as fórmulas e prescrições.
A balança começou a pender ao nosso favor somente depois que Alexander Fleming descobriu o primeiro antibiótico moderno a ser utilizado com sucesso: a penicilina.
Apesar do famoso médico inglês John Tyndall, em 1875, ter percebido a “luta” entre as bactérias e o mofo em seus experimentos e se restringido à mera apreciação, ficou para Fleming a descoberta do poder antibacteriano do fungo Penicillium notatum.
Nascido em Lochfield, Escócia, em 1881, Alexander Fleming frequentou a Universidade de Londres e escolheu o Hospital Saint Mary para o seu treinamento e com muito esforço foi nomeado diretor assistente do Departamento de Inoculação do hospital.

Sir Alexander Fleming (1881-1955). Juntamente com Chain e Florey, recebeu o Prêmio Nobel de Medicina de 1945.
Saindo de férias – em 1928 – deixou a bandeja na bancada do laboratório, onde cultivava em placas de Petri a bactéria patogênica Staphylococcus aureus (aquela encontrada em menor quantidade em pessoas com barba) e alguns fatores promoveram a proliferação do fungo:
- Poucas espécies de Penicillium produzem substâncias antibióticas e o Penicillium notatum é uma delas. Logo abaixo do laboratório de Fleming um especialista em bolores estava trabalhando com esta espécie, cultivando tais fungos amplamente. Se o fungo não fosse especificamente este ou se o laboratório de bolores não ficasse exatamente abaixo, os esporos não chegariam à quantidade suficiente para contaminar a placa de cultura.
- Por serem deixadas à temperatura ambiente as bactérias proliferaram em grande quantidade, que poderia ser muito maior e em maior velocidade se a placa fosse deixada na estufa – que estava igualada à temperatura corporal humana.
- Se bactérias imunes à ação antimicrobiana do Penicillium fossem inoculadas na placa, efeito nenhum seria notado.
- Os esporos do fungo caíram exatamente no momento em que ele esfregava os Estafilococos na placa de ágar. Se estes esporos tivessem caído sobre a placa horas depois da inoculação, com as bactérias cultivadas já se desenvolvendo, o crescimento destas impediria a multiplicação do fungo.
- Geralmente Fleming costumava colocar as bandejas inoculadas na incubadora, porém, sabendo que as bactérias iriam se proliferar o suficiente durante o período das suas férias, não fez o que era de costume. Sem saber que o mofo Penicillium crescia exageradamente em temperatura ambiente e não crescia na incubadora, ele ajudou o desenvolvimento das colônias do fungo.
- Uma intensa onda de calor atingiu Londres, forte o suficiente para igualar as temperaturas do ambiente e da incubadora. No dia exato em que ele cultivou as bactérias e acidentalmente os esporos entraram em contato com a placa, esta onda de calor cessou, abaixando a temperatura do laboratório, que se manteve, permitindo que os esporos crescessem durante o período das suas férias.
Ao voltar em setembro de 1928 das suas férias Fleming percebeu que, apesar do grande crescimento de Estafilococos na placa, uma ampla área em volta do crescimento circular do mofo não apresentou bactérias. Alec tinha percebido que naquele fungo existia algo que a lisozima – importante proteína do sistema imune presente em nossas secreções, descoberta por ele – nunca havia feito: atacado o tipo mais comum e mais perigoso de bactérias, as temidas e virulentas bactérias esféricas que crescem em feixes semelhantes a um cacho de uva, conhecidas como Estafilococos.

Reconstrução do recipiente de cultura no qual Fleming viu pela primeira vez a penicilina. No canto esquerdo a a colônia do fungo. O soro – a penicilina – está brotando dele. À direita vê-se a área em que as colônias de Estafilococos estavam transparentes e se dissolvendo. Mais à direita as bactérias que se desenvolveram, por estarem fora do alcance da penicilina.
Antes disso o tratamento antisséptico, introduzido por Joseph Lister (daí o nome do famoso enxaguante bucal) em 1865 para tratar feridas e pacientes em pós-operatórios, já salvava vidas , porém ficou para a penicilina o tratamento das doenças já instaladas, mudando para sempre as relações entre as infecções e o ser humano.

Joseph Lister (1827-1912) removendo os curativos do jovem James Greenlees, vítima de fratura exposta. Devido à anti-sepsia, a ferida estava curada e sem infecção.
O isolamento, a purificação, a produção e os testes realizados em animais, feitos realizados por Howard Florey, Ernst Chain e uma grande quantidade de pesquisadores de Oxford, foram procedimentos difíceis pela quais todos desta equipe passaram. Para isso os laboratórios da Escola de Patologia Willian Dunn se transformaram numa verdadeira fábrica de penicilina. Latas de óleo, recipientes de lixo, banheiras domésticas, tambores de leite, tudo utilizado para produzir uma quantidade suficiente de soro a partir do fungo da penicilina. Em março de 1940, Chain conseguiu extrair uma quantidade suficiente de penicilina para ser testada em animais, obtendo 100 miligramas, na forma de um pó de coloração marrom. Mesmo neste estado a droga continuava sendo inofensiva para os animais, células de defesa e tecidos vivos do organismo. Em 25 de maio de 1940 testes foram realizados em oito ratos brancos, podendo a equipe determinar com que frequência, por quanto tempo e em que doses deveria ser administrada.

Á esquerda Howard Walter Florey (1898-1968), farmacêutico australiano e à direita Ernst Boris Chain (1906-1979), bioquímico alemão. Ambos receberam, juntamente com Fleming, o Prêmio Nobel de Medicina de 1945.
Quanto mais era estudado, mais promissor se tornava este fungo, que começou a dar resultados em humanos. Em 12 de fevereiro de 1941, a equipe tratou seu primeiro paciente: era o policial Albert Alexander, que havia se ferido numa roseira e se infectado por bactérias. Vinte e quatro horas após a primeira injeção houve uma grande melhora no quadro do paciente. Porém para cura completa o medicamento deveria permanecer tempo suficiente no corpo, o que não aconteceu com o policial, que, não recebendo mais doses de penicilina por indisponibilidade da mesma, foi atacado novamente pelas bactérias e morreu no dia 15 de março do mesmo ano. O primeiro sucesso veio no segundo paciente: um garoto de 15 anos que estava morrendo por uma infecção pós-operatória, e após ser tratado com a penicilina, se recuperou totalmente. Mas sabendo que esses casos eram insuficientes para convencer o mundo e que no mínimo uma centena de pacientes precisaria do tratamento, chegaram à conclusão que seriam necessários dois mil litros de soro para tratar um único caso grave. Não conseguindo ajuda dos laboratórios farmacêuticos ingleses, a equipe procurou os Estados Unidos. A produção iniciou lá, num laboratório de pesquisas agrícolas em Peoria, Illinois, e espalhou-se pelo mundo, conquistando de vez as indústrias farmacêuticas.
Pelo sucesso dos resultados o cirurgião geral da U.S. Army autorizou o uso do antibiótico em um Hospital Militar, posteriormente sendo adotado por todos os serviços médicos das Forças Armadas dos Estados Unidos. Apesar de não curar todas as doenças infecciosas bacterianas, a substância já curou milhões de infecções incluindo a pneumonia, sífilis, difteria, escarlatina, gonorreia, febre reumática, septicemia, gangrena, e até mesmo meningite, bronquite e infecções nos ossos.
Outro benefício importante notado por Fleming foi que o fungo, por destruir todas as bactérias, exceto algumas bactérias como o bacilo de Pferiffer (que, segundo os cientistas da época, causava a gripe), poderia ser usado como uma espécie de “depurador”. Essa propriedade foi importante para isolar este bacilo e outras bactérias, como a que causava a coqueluche infantil, auxiliando na produção de vacinas para este doença
O desenvolvimento de penicilinas semissintéticas, como a estreptomicina, criada por Selman Waksman, foi importante no tratamento de tuberculose e em outras infecções bacterianas que não reagiam à penicilina.

Selman Abraham Waksman (1888-1973), bioquímico norte-americano, premiado com o Prêmio Nobel de Medicina em 1952. Especialista em microbiologia do solo, Waksman inspirou-se no descobrimento da penicilina para obter a estreptomicina.
Atualmente, pelo menos 30% de todos os pacientes hospitalizados são tratados com um ou mais esquemas terapêuticos com antibióticos.
A descoberta da penicilina foi um dos maiores avanços da humanidade, e, como a maioria das descobertas científicas também apresenta desvantagens quando aplicada de forma incorreta: o uso indiscriminado de antibióticos para tratamento de infecções não bacterianas como gripes e a maioria das diarreias; a interrupção do tratamento antes do prazo determinado pelo médico e a automedicação tem selecionado bactérias cada vez mais resistentes a estes fármacos, diminuindo e até anulando os efeitos terapêuticos dos antibióticos sobre o organismo. Isso transforma a história dos antimicrobianos em cada vez mais dinâmica, caracterizada pelo surgimento constante de novos desafios, promovendo investigação, descoberta e produção de novas drogas para vencer as chamadas superbactérias. Quer saber mais sobre as superbactérias? Escutem o Scicast #11 e #12
Fontes:
- Alexandre Fleming: A Descoberta da Penicilina
- Alexander Fleming e os antibióticos. FRIEDMAN, Meyer. FRIEDLAND, Gerald. W. As Dez Maiores Descobertas da Medicina. Tradução José Rubens Siqueira. Revisão técnica Drauzio Varella. 1ª edição. São Paulo: Editora Companhia das Letras, 2001. Cap. 9. p243-276.
- Lister Introduz a Anti-Sepsia. Santo Amaro: n. 67, jan./fev. 1984.
- Nos Dias do Papiro de Ebers. Santo Amaro: n. 49, jul. 1981.
- Filho IJ. A DESCOBERTA DOS ANTIBIÓTICOS. Revista Ser Médico Out./Nov./Dez de 2001; Ano IV; Nº 17.
- GUIA DOS CURIOSOS. Antibióticos. Desenvolvido por Marcelo Duarte
- MUSEU DA VIDA – FIOCRUZ. “É um milagre!”. Desenvolvido por Maria Ramos
- NOVA ESCOLA ON-LINE. Penicilina, o grande legado de Alexander Fleming.
- PERSONAGENS QUE MUDARAM O MUNDO, OS GRANDES CIENTISTAS. ALEXANDER FLEMING. Rio de Janeiro: Editora Globo, 1993.
- SANDE, MERLE. Fármacos Antimicrobianos. In: GOODMAN, ALFRED. As Bases Farmacológicas da Terapêutica. 8ª edição. Rio de Janeiro: Guanabara Koogan S.A., 1991. p675.
- UNESP. O mundo do horror. Desenvolvido por Evanildo da Silveira.











